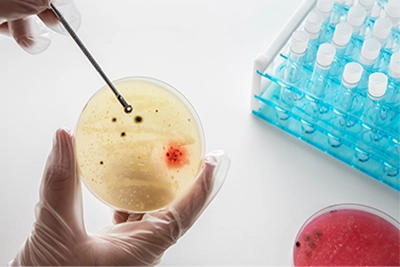
Microbiological Testing

Perspective and Deliverables
We at Akums believe that customer centric deliverables and our Quality Management System (QMS) is designed to ensure that every product we manufacture fulfil the quality standards of current national and international regulatory requirements.
We have established robust procedures to assure end-to-end quality standards by keeping patient health and safety in mind, covering all stages of the product lifecycle, from development, validation, stability and commercialization. Committed to ensure the stability of product throughout shelf life.